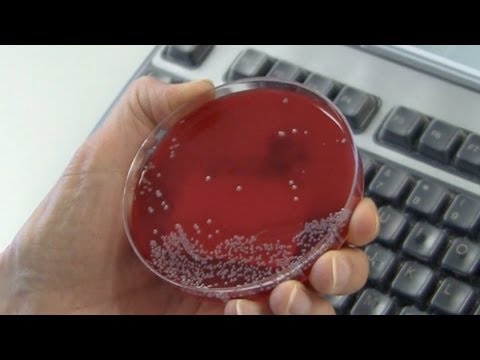

Video describes why biopsy results take so long (up to 7 days). Take a look at the behind the scenes for how surgical specimens are processed to give a diagnosis DAYS later rather than the 24 hours most patients and families hope/expect. Video produced by Dr. Chris Chang: Still haven’t subscribed to Fauquier ENT on YouTube? ►► #pathology #path #biopsy
- 358904Просмотров
- 1 десятилетие назадОпубликованоFauquier ENT
Why Do Biopsy Results Take So Long? (How Long? Up to 7 Days)
Похожее видео
Популярное
винни пух ну погоди
Городской снайпер 1 серия
Лихач 2025
Красная гадюка 23 серия
Кормление
Красная гадюка 12 серія
красная гадюка 12
Mufasa the lion king shaju
Потераний снайпер 2
лалапупси реклама
feet city
детский сад
Грань правосудия 4 сезон
ПОТЕРЯННЫЙ СНАЙПЕР 5 сери
красный тигр
ПЕРСИ И ЕГО ДРУЗЬЯ
Menu dvd Lex olivie remake monstros sa
Смешарики титры
ЕДУНОВ ВИДИО
Я жена вашего мужа
паляниця
реклама для детей
Universal picturesworkingtitie nanny McPhee
союзмультфильм игрушки
Красная гадюка 13серия
Городской снайпер 1 серия
Лихач 2025
Красная гадюка 23 серия
Кормление
Красная гадюка 12 серія
красная гадюка 12
Mufasa the lion king shaju
Потераний снайпер 2
лалапупси реклама
feet city
детский сад
Грань правосудия 4 сезон
ПОТЕРЯННЫЙ СНАЙПЕР 5 сери
красный тигр
ПЕРСИ И ЕГО ДРУЗЬЯ
Menu dvd Lex olivie remake monstros sa
Смешарики титры
ЕДУНОВ ВИДИО
Я жена вашего мужа
паляниця
реклама для детей
Universal picturesworkingtitie nanny McPhee
союзмультфильм игрушки
Красная гадюка 13серия
Новини